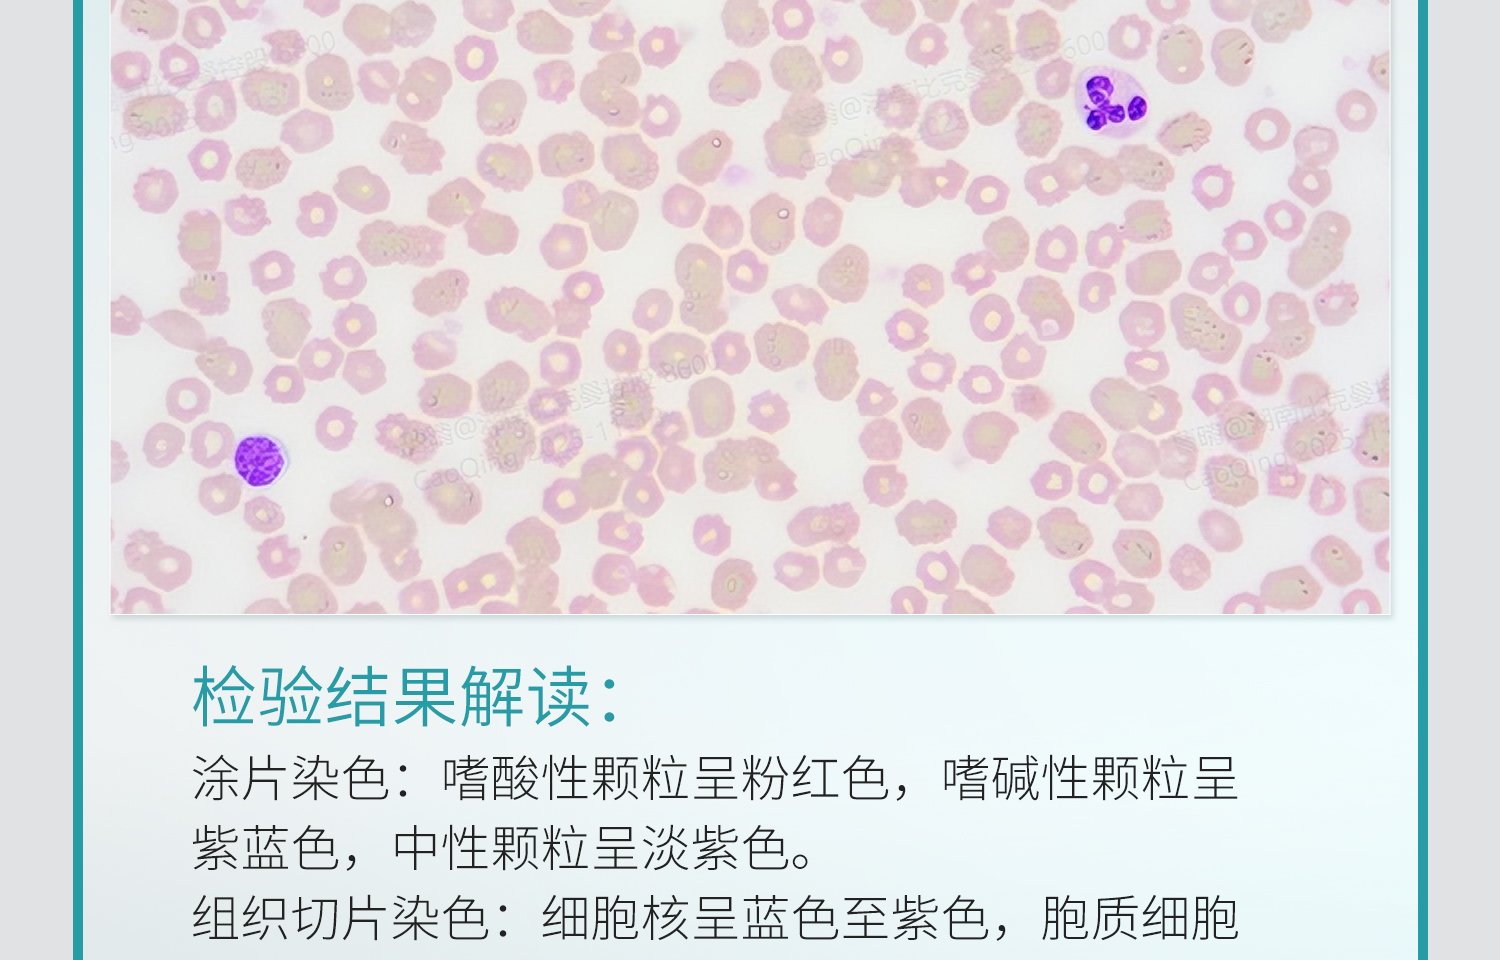
BKM-姬姆萨染色液详情_13.jpg
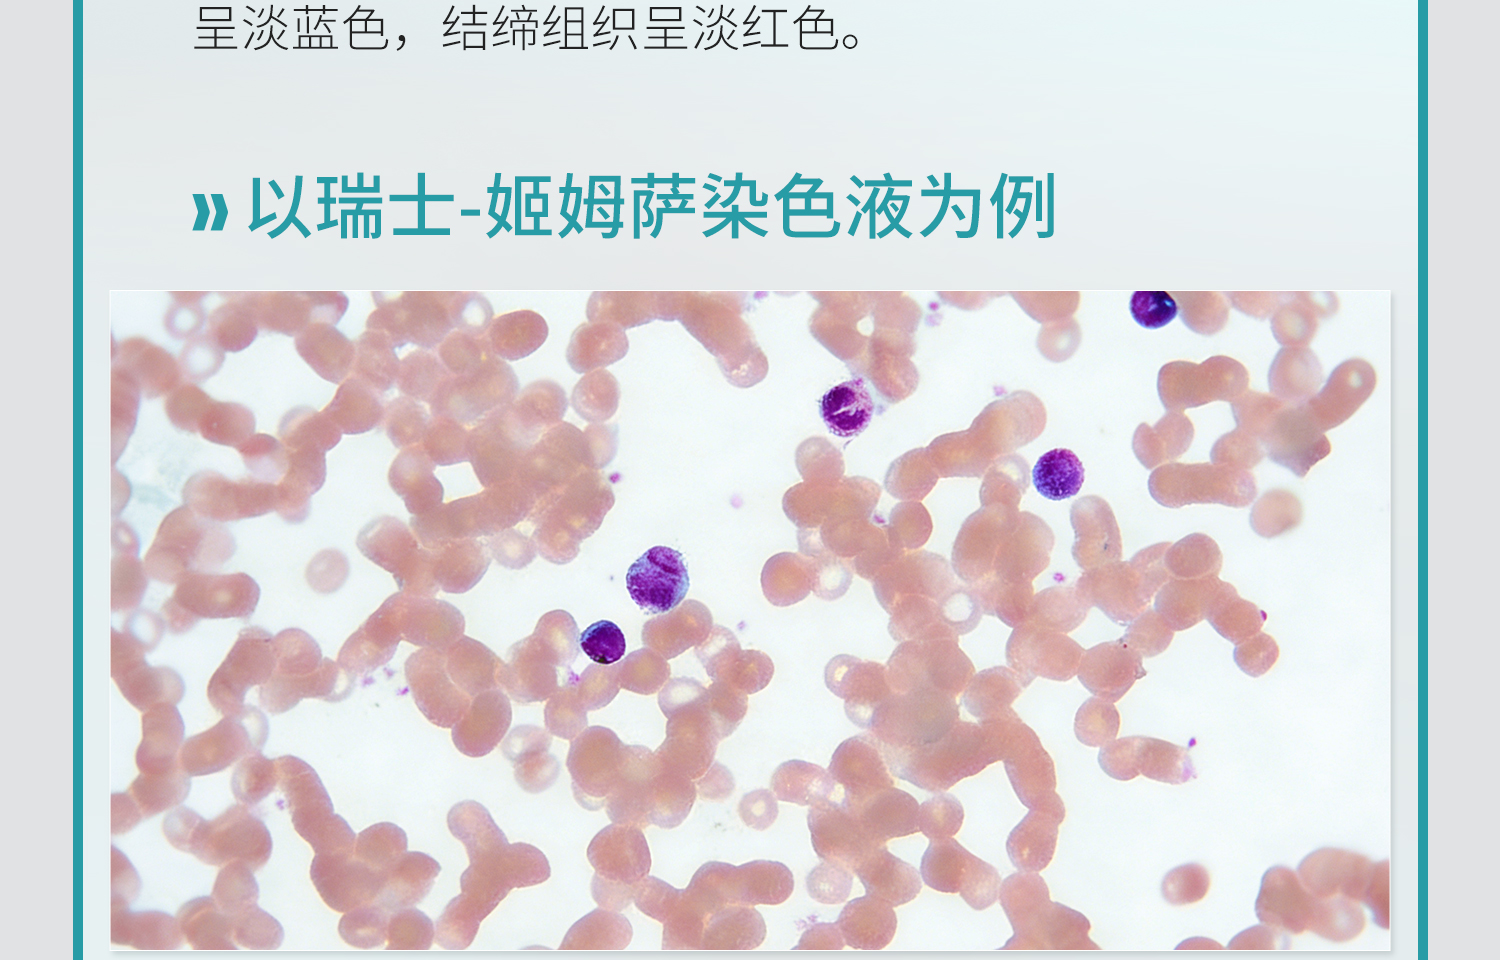
BKM-姬姆萨染色液详情_14.jpg

中文版
English
加入收藏
瑞氏姬姆萨染色液
产品名称:瑞氏姬姆萨染色液
产品品牌:BKMAMLAB
产品规格:
-
瑞氏染色液100ml*4/盒 110703022
-
瑞氏染色液20ml*4/盒 110703023
-
瑞氏染色液250ml*2 110703024
-
姬姆萨染色液100ml*4/盒 110703005
-
姬姆萨染色液20ml*4/盒 110703006
-
姬姆萨染色液250ml*2瓶/盒 110703071
-
姬姆萨染色液100ml*2瓶/套 110703072
-
瑞氏染色液100mL*2瓶/套 110703073
-
瑞氏-姬姆萨染色液20ML*4/盒 110703068
-
瑞氏-姬姆萨染色液100ML*4/盒 110703069
-
瑞氏-姬姆萨染色液250ML*4/盒 110703070